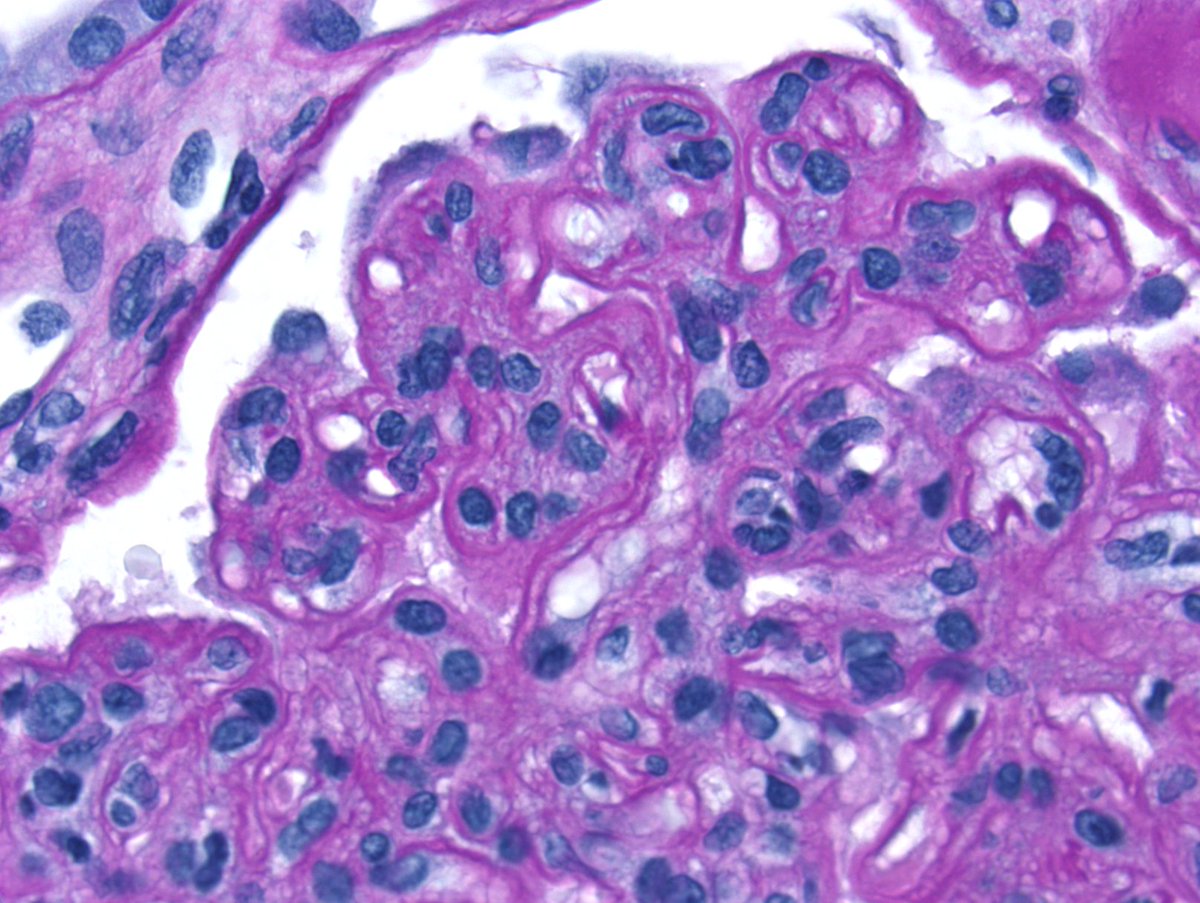
Nice example of chronic active antibody-mediated rejection with transplant glomerulopathy (and severe arteriolar hyalinosis from years of CNI use). Plenty of double contours and glomerulitis! #RenalPath

Kuang-Yu Jen, MD, PhD
@kidneypath
Professor, Department of Pathology, Director of Renal Pathology, UC Davis Medical Center, @UCDPath, @UCDavisHealth, #RenalPath
ID: 986636513403256832
18-04-2018 16:04:10
132 Tweet
1,1K Takipçi
50 Takip Edilen

Just wanted to spread the word that UC Davis Pathology is hiring renal pathologists! Please see link below if interested: recruit.ucdavis.edu/JPF04976 #RenalPath